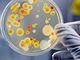

Archivio 24 Ore
sabato 20 dicembre
venerdì 19 dicembre
24 Ore | mercoledì 03 novembre
(h. 10:49)
La Struttura di Radiologia dell'ospedale Parini di Aosta è a rischio collasso. Alle carenze di personale tecnico pre-pandemia si sono aggiunte le...
(h. 07:42)
Cambiano sede gli ambulatori della struttura semplice di Microbiologia. Lunedì prossimo, 8 novembre, inizieranno infatti le operazioni di trasloco...